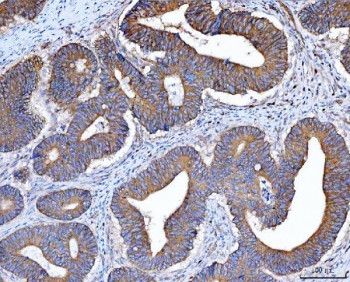
Anti-Src

Cookie preferences
This website uses cookies, which are necessary for the technical operation of the website and are always set. Other cookies, which increase the comfort when using this website, are used for direct advertising or to facilitate interaction with other websites and social networks, are only set with your consent.
Configuration
Technically required
These cookies are necessary for the basic functions of the shop.
"Allow all cookies" cookie
"Decline all cookies" cookie
CSRF token
Cookie preferences
Currency change
Customer-specific caching
FACT-Finder tracking
Individual prices
Selected shop
Session
Comfort functions
These cookies are used to make the shopping experience even more appealing, for example for the recognition of the visitor.
Note
Show the facebook fanpage in the right blod sidebar
Statistics & Tracking
Affiliate program
Conversion and usertracking via Google Tag Manager
Track device being used
| Item number | Size | Datasheet | Manual | SDS | Delivery time | Quantity | Price |
|---|---|---|---|---|---|---|---|
| NSJ-R31489 | 100 µg | - | - |
3 - 10 business days* |
790.00€
|
If you have any questions, please use our Contact Form.
You can also order by e-mail: info@biomol.com
Larger quantity required? Request bulk
You can also order by e-mail: info@biomol.com
Larger quantity required? Request bulk
0.5mg/ml if reconstituted with 0.2ml sterile DI water. Sarcoma is a proto-oncogenic tyrosine... more
Product information "Anti-Src"
0.5mg/ml if reconstituted with 0.2ml sterile DI water. Sarcoma is a proto-oncogenic tyrosine kinase originally discovered by J. Michael Bishop and Harold E. Varmus. It belongs to a family of non-receptor tyrosine kinases called Src family kinases. The human proto-oncogene was assigned to chromosome 20. Its gene is mapped to 20q12-q13. The discovery of Src family proteins has been instrumental to the modern understanding of cancer as a disease where normally healthy cellular signalling has gone awry. This proto-oncogene may play a role in the regulation of embryonic development and cell growth. Protein function: Non-receptor protein tyrosine kinase which is activated following engagement of many different classes of cellular receptors including immune response receptors, integrins and other adhesion receptors, receptor protein tyrosine kinases, G protein-coupled receptors as well as cytokine receptors. Participates in signaling pathways that control a diverse spectrum of biological activities including gene transcription, immune response, cell adhesion, cell cycle progression, apoptosis, migration, and transformation. Due to functional redundancy between members of the SRC kinase family, identification of the specific role of each SRC kinase is very difficult. SRC appears to be one of the primary kinases activated following engagement of receptors and plays a role in the activation of other protein tyrosine kinase (PTK) families. Receptor clustering or dimerization leads to recruitment of SRC to the receptor complexes where it phosphorylates the tyrosine residues within the receptor cytoplasmic domains. Plays an important role in the regulation of cytoskeletal organization through phosphorylation of specific substrates such as AFAP1. Phosphorylation of AFAP1 allows the SRC SH2 domain to bind AFAP1 and to localize to actin filaments. Cytoskeletal reorganization is also controlled through the phosphorylation of cortactin (CTTN) (Probable). When cells adhere via focal adhesions to the extracellular matrix, signals are transmitted by integrins into the cell resulting in tyrosine phosphorylation of a number of focal adhesion proteins, including PTK2/FAK1 and paxillin (PXN) (PubMed:21411625). In addition to phosphorylating focal adhesion proteins, SRC is also active at the sites of cell-cell contact adherens junctions and phosphorylates substrates such as beta-catenin (CTNNB1), delta-catenin (CTNND1), and plakoglobin (JUP). Another type of cell- cell junction, the gap junction, is also a target for SRC, which phosphorylates connexin-43 (GJA1). SRC is implicated in regulation of pre-mRNA-processing and phosphorylates RNA-binding proteins such as KHDRBS1 (Probable). Also plays a role in PDGF-mediated tyrosine phosphorylation of both STAT1 and STAT3, leading to increased DNA binding activity of these transcription factors. Involved in the RAS pathway through phosphorylation of RASA1 and RASGRF1 (PubMed:11389730). Plays a role in EGF-mediated calcium- activated chloride channel activation (PubMed:18586953). Required for epidermal growth factor receptor (EGFR) internalization through phosphorylation of clathrin heavy chain (CLTC and CLTCL1) at 'Tyr- 1477'. Involved in beta-arrestin (ARRB1 and ARRB2) desensitization through phosphorylation and activation of GRK2, leading to beta- arrestin phosphorylation and internalization. Has a critical role in the stimulation of the CDK20/MAPK3 mitogen-activated protein kinase cascade by epidermal growth factor (Probable). Might be involved not only in mediating the transduction of mitogenic signals at the level of the plasma membrane but also in controlling progression through the cell cycle via interaction with regulatory proteins in the nucleus (PubMed:7853507). Plays an important role in osteoclastic bone resorption in conjunction with PTK2B/PYK2. Both the formation of a SRC- PTK2B/PYK2 complex and SRC kinase activity are necessary for this function. Recruited to activated integrins by PTK2B/PYK2, thereby phosphorylating CBL, which in turn induces the activation and recruitment of phosphatidylinositol 3-kinase to the cell membrane in a signaling pathway that is critical for osteoclast function (PubMed:8755529, PubMed:14585963). Promotes energy production in osteoclasts by activating mitochondrial cytochrome C oxidase (PubMed:12615910). Phosphorylates DDR2 on tyrosine residues, thereby promoting its subsequent autophosphorylation (PubMed:16186108). Phosphorylates RUNX3 and COX2 on tyrosine residues, TNK2 on 'Tyr-284' and CBL on 'Tyr-731' (PubMed:20100835, PubMed:21309750). Enhances DDX58/RIG-I-elicited antiviral signaling (PubMed:19419966). Phosphorylates PDPK1 at 'Tyr-9', 'Tyr-373' and 'Tyr-376' (PubMed:14585963). Phosphorylates BCAR1 at 'Tyr-128' (PubMed:22710723). Phosphorylates CBLC at multiple tyrosine residues, phosphorylation at 'Tyr-341' activates CBLC E3 activity (PubMed:20525694). Phosphorylates synaptic vesicle protein synaptophysin (SYP). Involved in anchorage-independent cell growth (PubMed:19307596). Required for podosome formation. Mediates IL6 signaling by activating YAP1-NOTCH pathway to induce inflammation-induced epithelial regeneration (PubMed:25731159). [The UniProt Consortium]
| Keywords: | Anti-SRC1, Anti-p60-Src, Anti-pp60c-src, Anti-Proto-oncogene c-Src, Anti-Proto-oncogene tyrosine-protein kinase Src, Src Antibody |
| Supplier: | NSJ Bioreagents |
| Supplier-Nr: | R31489 |
Properties
| Application: | WB, IHC (paraffin), FC |
| Antibody Type: | Polyclonal |
| Conjugate: | No |
| Host: | Rabbit |
| Species reactivity: | human |
| Immunogen: | Human partial recombinant protein (AA 2-368) |
| Format: | Tyrosine Phosphorylation |
Database Information
| KEGG ID : | K05704 | Matching products |
| UniProt ID : | P12931 | Matching products |
| Gene ID : | GeneID 6714 | Matching products |
Handling & Safety
| Storage: | +4°C |
| Shipping: | +4°C (International: +4°C) |
Caution
Our products are for laboratory research use only: Not for administration to humans!
Our products are for laboratory research use only: Not for administration to humans!
Information about the product reference will follow.
more
You will get a certificate here
Viewed